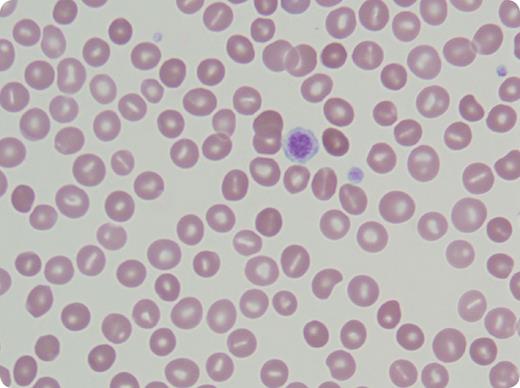
A 47-year-old white male was referred for chronic thrombocytopenia of 80-90 × 109/L and splenomegaly since 1997. He had been treated unsuccessfully, and mistakenly, for immune thrombocytopenia (steroids, rituximab, romiplostim, and anti-D that produced severe hemolysis requiring hospitalization). Previous bone marrow biopsies were nondiagnostic and an earlier liver biopsy showed steatosis. A cholecystectomy had been performed for gallstones. Family history was negative. In addition to mild splenomegaly, he presented with xanthomas. Labs showed hemoglobin 12.3 g/dL, haptoglobin 2 mg/dL, indirect bilirubin 2.4 mg/dL, and an elevated absolute reticulocyte count 240 mil/L. Direct antiglobulin test and flow cytometry for paroxysmal nocturnal hemoglobinuria were negative. Osmotic fragility was increased. Peripheral smear revealed stomatocytes and macrothrombocytes (see figure) consistent with hereditary sitosterolemia. The patient's sitosterol level was 166.0 mg/L (0-5) and campesterol 84.9 mg/L (0-7). / Sitosterolemia is a rare autosomal recessive disorder involving the ATP-Binding Cassette G (ABCG) proteins ABCG5 and ABCG8 that help prevent sterol absorption and promote excretion of plant sterols. Absent their function, plant sterols accumulate in the blood and onto the red cell membrane inner layer, resulting in stomatocytes. The mechanism of macrothrombocytes is not understood, but the total platelet mass is usually normal. These proteins are not expressed on red blood cells or platelets. The morphologic defects are acquired. Examination of the peripheral smear led to diagnosis of sitosterolemia, the syndrome of stomatocytes, hemolytic anemia, thrombocytopenia, and macrothrombocytes.

A 47-year-old white male was referred for chronic thrombocytopenia of 80-90 × 109/L and splenomegaly since 1997. He had been treated unsuccessfully, and mistakenly, for immune thrombocytopenia (steroids, rituximab, romiplostim, and anti-D that produced severe hemolysis requiring hospitalization). Previous bone marrow biopsies were nondiagnostic and an earlier liver biopsy showed steatosis. A cholecystectomy had been performed for gallstones. Family history was negative. In addition to mild splenomegaly, he presented with xanthomas. Labs showed hemoglobin 12.3 g/dL, haptoglobin 2 mg/dL, indirect bilirubin 2.4 mg/dL, and an elevated absolute reticulocyte count 240 mil/L. Direct antiglobulin test and flow cytometry for paroxysmal nocturnal hemoglobinuria were negative. Osmotic fragility was increased. Peripheral smear revealed stomatocytes and macrothrombocytes (see figure) consistent with hereditary sitosterolemia. The patient's sitosterol level was 166.0 mg/L (0-5) and campesterol 84.9 mg/L (0-7).
Sitosterolemia is a rare autosomal recessive disorder involving the ATP-Binding Cassette G (ABCG) proteins ABCG5 and ABCG8 that help prevent sterol absorption and promote excretion of plant sterols. Absent their function, plant sterols accumulate in the blood and onto the red cell membrane inner layer, resulting in stomatocytes. The mechanism of macrothrombocytes is not understood, but the total platelet mass is usually normal. These proteins are not expressed on red blood cells or platelets. The morphologic defects are acquired. Examination of the peripheral smear led to diagnosis of sitosterolemia, the syndrome of stomatocytes, hemolytic anemia, thrombocytopenia, and macrothrombocytes.
A 47-year-old white male was referred for chronic thrombocytopenia of 80-90 × 109/L and splenomegaly since 1997. He had been treated unsuccessfully, and mistakenly, for immune thrombocytopenia (steroids, rituximab, romiplostim, and anti-D that produced severe hemolysis requiring hospitalization). Previous bone marrow biopsies were nondiagnostic and an earlier liver biopsy showed steatosis. A cholecystectomy had been performed for gallstones. Family history was negative. In addition to mild splenomegaly, he presented with xanthomas. Labs showed hemoglobin 12.3 g/dL, haptoglobin 2 mg/dL, indirect bilirubin 2.4 mg/dL, and an elevated absolute reticulocyte count 240 mil/L. Direct antiglobulin test and flow cytometry for paroxysmal nocturnal hemoglobinuria were negative. Osmotic fragility was increased. Peripheral smear revealed stomatocytes and macrothrombocytes (see figure) consistent with hereditary sitosterolemia. The patient's sitosterol level was 166.0 mg/L (0-5) and campesterol 84.9 mg/L (0-7).
Sitosterolemia is a rare autosomal recessive disorder involving the ATP-Binding Cassette G (ABCG) proteins ABCG5 and ABCG8 that help prevent sterol absorption and promote excretion of plant sterols. Absent their function, plant sterols accumulate in the blood and onto the red cell membrane inner layer, resulting in stomatocytes. The mechanism of macrothrombocytes is not understood, but the total platelet mass is usually normal. These proteins are not expressed on red blood cells or platelets. The morphologic defects are acquired. Examination of the peripheral smear led to diagnosis of sitosterolemia, the syndrome of stomatocytes, hemolytic anemia, thrombocytopenia, and macrothrombocytes.
For additional images, visit the ASH IMAGE BANK, a reference and teaching tool that iscontinually updated with new atlas and case study images. For more information visit http://imagebank.hematology.org.
This feature is available to Subscribers Only
Sign In or Create an Account Close Modal